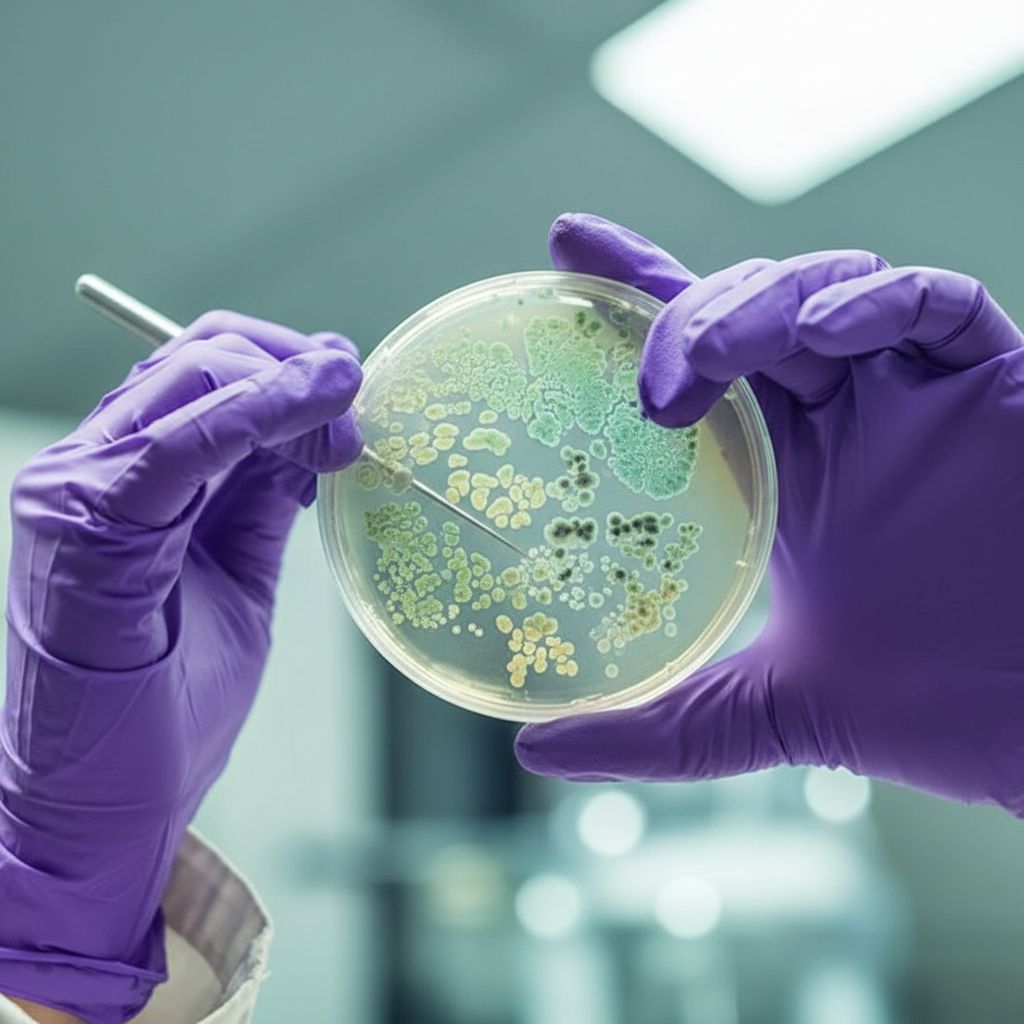

БЛОГ ЭКСПЕРТОВ ПО ЛЕЧЕНИЮ ЗА РУБЕЖОМ

18.10.2023
Больница Тэгу Фатима — это путь к здоровью!
31.03.2023
Как проходит лечение рака желудка в Корее?
07.08.2021
Как лечат женский рак в Корее?
17.05.2021
Как поехать на лечение в Корею в 2021 году?
28.01.2020
Секреты здоровья сердца!
24.01.2020
Все, что нужно знать об оливковом масле!
15.01.2020
7 поразительных свойств кокоса!
27.12.2019
Может ли куркума вылечить псориаз?
06.12.2019
Что нужно знать о болезни Лайма?
29.11.2019
Пуповинная кровь может спасти жизнь!
26.11.2019
Почему стоить лечить онкологию в Корее?
14.11.2019
Риски использования медицинских устройств!
25.10.2019
Взаимосвязь между деменцией и потерей слуха
22.02.2019
11 богатых железом продуктов для малышей!
13.02.2019
Что такое аллергия на кофеин?
01.02.2019
Основные причины боли в костях
01.02.2019
Работает ли щелочная диета?
25.01.2019
Какие симптомы при раке молочной железы?
17.01.2019
Что делать, если химиотерапия не помогает?
10.01.2019
Что такое нейтрофилы и каковы их функции?
27.12.2018
Убить рак всего одной инъекцией!
17.12.2018
Какие продукты защищают печень?